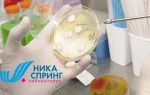

Показания
Микодерил доступен в двух формах – крем и лак (раствор). Их использование оправдано при следующих заболеваниях:
- грибковые инфекции гладкой кожи;
- микозы, затрагивающие область между пальцами;
- грибок ногтей, о котором можно узнать больше здесь;
- кандидоз кожных покровов;
- отрубевидный лишай;
- дерматомикозы воспалительного характера.
Кроме того, раствор Микодерила имеет и дополнительные показания: микозы, вызывающие поражение кожи с гиперкератозом.
Врачи отмечают, что средство Микодерил эффективно в борьбе с грибковыми инфекциями, особенно при поражении ногтей и кожи. Основным активным компонентом является аморолфин, который обладает фунгицидным и фунгистатическим действием, что позволяет не только уничтожать грибки, но и предотвращать их дальнейшее размножение. Специалисты рекомендуют использовать Микодерил при первых признаках грибка, таких как изменение цвета ногтей, их утолщение или ломкость. Важно соблюдать курс лечения, который может длиться от нескольких недель до нескольких месяцев, в зависимости от степени поражения. Врачи подчеркивают, что для достижения наилучших результатов необходимо сочетать применение препарата с соблюдением гигиенических мер и, при необходимости, консультацией с дерматологом.

Состав
При анализе раствора для наружного использования, можно отметить, что его формула включает активное вещество нафтифин гидрохлорид в количестве 10 мг. Кроме того, в состав входят несколько вспомогательных компонентов: пропиленгликоль, этиловый спирт и очищенная вода.
Что касается крема, то он также содержит то же самое активное вещество, а среди дополнительных ингредиентов можно выделить:
- натрия гидроксид;
- бензиловый спирт;
- сорбитана стеарат;
- цетилпальмитат;
- полисорбат;
- цетостеариловый спирт;
- изопропилмиристат;
- очищенная вода.
| Показания к применению | Форма выпуска | Способ применения |
|---|---|---|
| Грибковые инфекции кожи (микозы) | Крем | Наносить тонким слоем на пораженные участки кожи 1 раз в день |
| Грибковые инфекции ногтей (онихомикозы) | Раствор для наружного применения | Наносить на пораженные ногти и кожу вокруг них 1 раз в день |
| Отрубевидный лишай | Крем | Наносить тонким слоем на пораженные участки кожи 1 раз в день |
| Кандидоз кожи | Крем | Наносить тонким слоем на пораженные участки кожи 1 раз в день |
| Дерматомикозы, вызванные чувствительными к нафтифину возбудителями | Крем, раствор | Согласно инструкции, в зависимости от формы выпуска и локализации поражения |
Особенности применения
Как правильно наносить крем? В первую очередь, необходимо подготовить ногтевую пластину. Для этого следует аккуратно обрезать и отшлифовать ее с помощью пилочки. После этого можно приступать к нанесению крема на ноготь, не забывая обработать окружающие участки кожи на 1 см вокруг. Это важно, так как грибок может находиться на близлежащих слоях дермы. Крем следует наносить дважды в день.
Производитель утверждает, что препарат действует мгновенно. Лечение необходимо продолжать до тех пор, пока не отрастет здоровый ноготь. После устранения всех симптомов, лечебный состав Микодерил нужно использовать еще в течение 2 недель, чтобы предотвратить рецидив.
Если у вас грибок кожи на стопах или руках, сначала тщательно вымойте пораженный участок. Затем нанесите крем, захватывая также и здоровые участки кожи. Продолжительность лечения составит 4 недели. Лечебный состав Микодерил следует применять даже после исчезновения симптомов еще около 2 недель.
Раствор Микодерил лучше использовать для лечения микозов в областях с волосами. Также этот медикамент в виде капель эффективен для воздействия на утолщенные кожные покровы и ногти. Перед нанесением лака необходимо удалить поврежденный ноготь с помощью пилки и ножниц. Затем положите на него марлю, смоченную в растворе, и зафиксируйте пластырем, чтобы лекарство не испарялось. Так следует ходить до вечера, после чего повязку нужно снять и наложить новую. Этот курс лечения продлится около полугода. После устранения симптомов грибка, лак следует наносить еще в течение 14 дней.
При микозе кожи капли нужно наносить на пораженные участки один раз в сутки. Перед этим кожа должна быть тщательно очищена и высушена. Наносимый состав должен также охватывать здоровые участки дермы. Продолжительность терапии составляет от 2 до 4 недель.
Микодерил — это популярное средство для лечения грибковых инфекций, и отзывы пользователей о нем в основном положительные. Многие отмечают его эффективность в борьбе с грибком ногтей и кожи. Пациенты подчеркивают, что препарат быстро проникает в пораженные участки и способствует улучшению состояния уже через несколько недель. Удобство применения также вызывает одобрение: средство легко наносится и быстро высыхает. Однако некоторые пользователи сообщают о необходимости длительного курса лечения для достижения полного результата. Важно отметить, что, как и любое другое средство, Микодерил может вызывать индивидуальные реакции, поэтому перед началом использования рекомендуется проконсультироваться с врачом. В целом, большинство людей довольны результатами и рекомендуют препарат как надежное средство в борьбе с грибком.

Побочные явления
Согласно мнениям экспертов, побочные эффекты при использовании этого препарата не фиксировались. В редких случаях у пациентов может наблюдаться сухость, жжение или покраснение кожи. Эти нежелательные реакции исчезают сразу после завершения курса лечения.
Кому нельзя использовать препарат
Микодерил не рекомендуется применять во время беременности и грудного вскармливания. Это связано с отсутствием исследований, проведенных на данной группе людей. Детям следует использовать Микодерил исключительно под контролем врача.
Препарат противопоказан людям, имеющим аллергию на нафтифин и другие его составляющие. Также строго запрещено наносить медикамент на участки кожи с ранами и царапинами.

Сравнение Микодерила с Экзодерилом
Что выбрать: Экзодерил или Микодерил? Для того чтобы определить, какой из этих средств более эффективен, стоит внимательно изучить их особенности. Состав этих двух препаратов практически одинаков, как и показания к применению, противопоказания и возможные побочные эффекты. Главное различие между ними заключается в стоимости. Микодерил является более доступным аналогом Экзодерила и может эффективно справляться с грибковыми инфекциями наравне с более дорогим препаратом.
Аналоги
Если по каким-либо причинам вам не удалось приобрести Микодерил, вы можете рассмотреть возможность использования его аналогов. Они значительно дешевле, но при этом их эффективность не уступает оригиналу. В аптеке доступны следующие альтернативы:
- Нитрофунгин–Нео. Этот лак представлен в упаковке объемом 25 мл и стоит 158 рублей.
- Тербизил. Лак, предназначенный для местного лечения грибка, имеет цену 72 рубля.
- Фуцис. Этот аналог выпускается в форме таблеток и эффективно борется с инфекциями, вызванными грибами рода кандида. Его стоимость составляет 41 рубль.
- Микоспор. Этот препарат доступен в виде крема и мази, содержащих бифоназол в качестве активного компонента. Он подходит для лечения грибка на ногтях и коже, а его цена составляет 370 рублей.
Сколько стоит
Стоимость Микодерила может варьироваться в зависимости от аптеки, в которой он был куплен. Лак можно приобрести за 500-600 рублей, тогда как крем обойдется в 600-800 рублей.
Отзывы
Елена, 45 лет: Сначала я использовала другой препарат для лечения грибка ногтей, на который потратила около 4 флаконов. Однако результата не было. После изучения отзывов в интернете я решила попробовать Микодерил в форме раствора. Я наносила его дважды в день на пораженный ноготь. Лечение продолжалось 4 месяца, пока не отрос здоровый ноготь.
Сергей, 56 лет: Во время визита к врачу он порекомендовал мне использовать Экзодерил. Однако его цена оказалась довольно высокой. В аптеке мне предложили более доступный аналог – Микодерил в виде крема. Я наносил его вечером на очищенную ногтевую пластину. После двух месяцев применения мне удалось остановить развитие грибка и предотвратить его распространение на соседние пальцы.
Вопрос-ответ
Как правильно наносить микодерил?
При поражении кожи Микодерил наносят 1 раз в день на пораженную поверхность кожи и прилегающие к ней участки, после тщательной очистки и высушивания, захватывая приблизительно 1 см здорового участка кожи по краям зоны поражения.
Какова длительность терапии раствором микодерил при грибке ногтя?
Длительность лечения: при дерматомикозах — 2-4 недели (при необходимости — до 8 недель), при кандидозах — 4 недели. При поражениях ногтей (онихомикозах) перед первым применением препарата максимально удаляют пораженную часть ногтя ножницами и пилкой для ногтей.
Что лучше от грибка ногтей: Ламизил или Экзодерил?
Что лучше: Ламизил или Экзодерил? Ламизил не применяется для лечения онихомикозов, а Экзодерил может использоваться как средство от грибка ногтей. Поэтому при грибке ногтя лучше применять Экзодерил, а при микозе кожи — обратить внимание на тип грибка и обратиться к врачу.
Советы
СОВЕТ №1
Перед началом использования Микодерила обязательно проконсультируйтесь с врачом. Он поможет определить, подходит ли это средство для вашего типа грибковой инфекции и даст рекомендации по правильному применению.
СОВЕТ №2
Соблюдайте регулярность применения препарата. Для достижения наилучших результатов важно наносить Микодерил в соответствии с инструкцией, не пропуская дни и не прекращая лечение преждевременно, даже если симптомы исчезли.
СОВЕТ №3
Обратите внимание на гигиену. Во время лечения грибка старайтесь поддерживать чистоту и сухость пораженных участков кожи или ногтей, чтобы предотвратить повторное заражение и ускорить процесс выздоровления.
СОВЕТ №4
Следите за состоянием ногтей и кожи после завершения курса лечения. Даже после исчезновения симптомов рекомендуется продолжать наблюдение за состоянием, чтобы вовремя заметить возможное повторное проявление грибка.